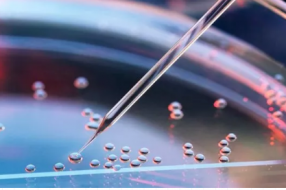
人工智能技术如何推动精准医疗的发展?

“精准医学”有时也被称为“个性化医学”,在医疗保健领域仍是一个相对较新的概念,但其基本思路多年之前就早已存在。根据美国国家医学图书馆的资料,精准医学是指“一种新兴的疾病治疗与预防方法,其考虑到每个人在基因、环境以及生活方式等方面的个体差异。”
精准医学能够帮助医生考量并采用更加个性化的治疗方法,而不再面向所有患者实施统一的治疗方法,从而确保治疗流程确切匹配病患的具体情况。在确定治疗方案的过程中,医生往往需要查看患者的遗传史、生活地区、环境因素、生活方式以及习惯等等。
借助人工智能技术,精准医学也迈入了新的阶段与高度,能够为患者提供更准确的预测性结论。同时,还有人认为,如果没有机器学习算法支持整个流程,精准医学根本不可能完全实现。
在由Chilmark Research发布一的份报告中,研究人员指出要充分发挥精准医学的潜力,除了以远超人类的速度读取并分析大量医学数据之外,AI技术还能够更准确地给出判结果,包括适用于患者的治疗选项以及可能的治疗结果等重要论断。
在AI的帮助下,我们不仅能够预测治疗效果,甚至有望预测患者未来患病的可能性,这也正是精准医学的一大核心优势。通过更透彻地理解为何发生疾病以及在哪些环境之下更可能产生疾病,人工智能得以帮助并引导医学从业者了解可以根据哪些发病前迹象实现疾病预判。对于医疗行业以及每一位普通人而言,这种提前评估疾病风险的能力无疑是革命性的。
此外,机器学习还有助于改善美国食品药物管理局(FDA)制定的关于测试、药物与药物合成合作关系的法规,进而支撑起更完善的治疗体系。更具体地讲,要全面实现精准医学,我们首先需要在各制药企业、生物技术公司、学术界、诊断机构等参与方之间建立起紧密的协作体系,从而推动创新工作的快速进步。
行业领先的精准医学情报公司Amplion最近发布了Dx:Revenue。这是一套软件情报平台,利用机器学习技术提供与各制药合作方相关的洞察见解。
这套平台覆盖包括临床试验、科学出版物、会议摘要、FDA批准测试、实验室测试以及其他信息的总计3400万个数据源,旨在确保测试服务供应商的能力与制药企业的特定需求相匹配。
Amplion公司CEO Chris Capdevlia表示,“这种能力在癌症领域尤其重要,因为我们正努力将以往千篇一律的匹配方法转化为更具针对性的个性化实施方向,从而根据每一位患者的生物学特征进行治疗。通过这种医疗保健个性化方法,我们不仅能够为患者带来更好的治疗结果,还能够通过降低周期与提高成功率的方式压缩药物开发成本,推动有价值药物的上市速度——这一切都将为患者带来更好的诊疗体验与治愈效果。”
精准医学有望真正改善民众的生活质量,甚至挽救更多生命。而人工智能的应用则能够显著放大这种积极效果。对于众多因目前诊疗费用及医疗保险额度而无法承担高复杂度治疗方法的患者,精准医学与AI技术的结合还能显著降低治疗的成本与享用门槛。诚然,精准医学仍然面临着诸多挑战,但我们相信人工智能的介入将帮助我们不断探索、最终实现这一伟大目标。